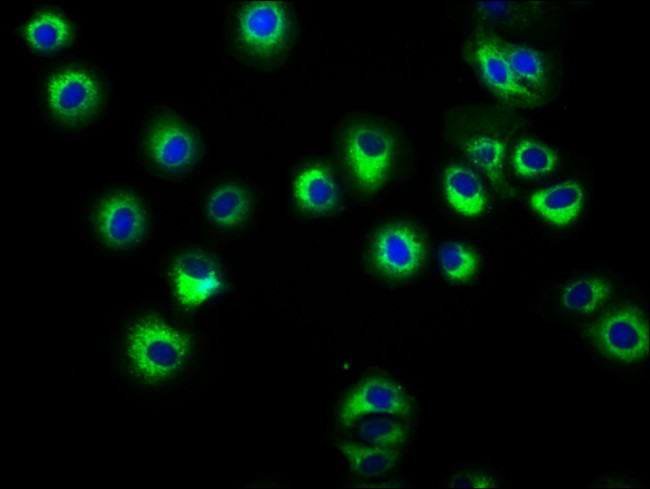
HLA-ABC Antibody in Immunocytochemistry (ICC/IF)

Search
Invitrogen
HLA-ABC Polyclonal Antibody
{{$productOrderCtrl.translations['antibody.pdp.commerceCard.promotion.promotions']}}
{{$productOrderCtrl.translations['antibody.pdp.commerceCard.promotion.viewpromo']}}
{{$productOrderCtrl.translations['antibody.pdp.commerceCard.promotion.promocode']}}: {{promo.promoCode}} {{promo.promoTitle}} {{promo.promoDescription}}. {{$productOrderCtrl.translations['antibody.pdp.commerceCard.promotion.learnmore']}}
图: 1 / 4
HLA-ABC Antibody (PA5-98355) in ICC/IF




Please note: We are reviewing Western blot images included in the antibody testing data in our catalog, including those provided by third parties. Unless expressly labeled or annotated as “raw-unedited”, Western blot images included in the antibody testing data in our catalog may have been edited, optimized or otherwise adjusted for presentation.
产品信息
PA5-98355
种属反应
已发表种属
宿主/亚型
分类
类型
抗原
偶联物
形式
浓度
规格
纯化类型
保存液
内含物
保存条件
运输条件
RRID
靶标信息
HLA-class I major histocompatibility (MHC) antigens are intrinsic membrane glycoproteins expressed on nucleated cells and noncovalently associated with an invariant beta2 microglobulin. They carry foreign determinants important for immune recognition by cytotoxic T cells, thus important for anti-viral and anti-tumor defense. Human HLA-class I antigens are represented by HLA-A, HLA-B and HLA-C molecules.
HLA and MHC antibodies play a significant role in Immunopeptidomics, facilitating the identification and characterization of neoantigens through high-performance liquid chromatography coupled to tandem Mass Spectrometry.
仅用于科研。不用于诊断过程。未经明确授权不得转售。
生物信息学
蛋白别名: allele B-3515; B*3509; cell surface glycoprotein; integral membrane protein; exons 2-8; glycosylation aa 86, alpha domain 1 aa 1-24, alpha domain 2 aa 25-114, alpha domain 3 aa 207-298; glycosylation aa 86, alpha domain 1 aa 25-114, alpha domain 2 aa 115-206, alpha domain 3 aa 207-298; H-2K; H-2K(d); H2-K; heavy chain; hla antigen; HLA B-1519; HLA class I antigen HLA-B; HLA class I histocompatibility antigen, A alpha chain; HLA class I histocompatibility antigen, A-1 alpha chain; HLA class I histocompatibility antigen, B alpha chain; HLA class I histocompatibility antigen, C alpha chain; HLA protein allele A25; HLA protein allele B37; HLA protein allele B51; HLA protein allele B57; HLA protein allele B7; HLA-A; HLA-A 2402; HLA-A*0201 alpha chain; human leukocyte antigen; HLA-A*0204; HLA-A*0207 alpha chain; human leukocyte antigen; HLA-A-0102 allele; HLA-A24AK; HLA-A25; HLA-B; HLA-B 1502; HLA-B*4002; HLA-B-07ZEL allele; HLA-B-1501; HLA-B-1516; HLA-B-1520 allele; HLA-B-15AOH allele; HLA-B-15ZEL allele; HLA-B-27KSH allele; HLA-B-67LAV allele; This submission reports an HLA-B-6701 variant (HLA-B-67LAV) that differs from the published B-6701 sequence, GenBank Accession Number L17005; HLA-B18; HLA-B27 peptide; HLA-B39; HLA-B41 variant; HLA-B61; HLA-Bw-39-DBU allele; HLA-C; HLA-C antigen; HLA-Cw; HLA-Cw1 protein; HLA-Cw2 protein; HLA-Cw3 protein; human leukocyte antigen; Human leukocyte antigen A; Human leukocyte antigen B; Human leukocyte antigen C; human leukocyte antigen-C alpha chain; leucocyte antigen A; leukocyte antigen class I-A; leukocyte antigen class I-B; lymphocyte antigen; major histocompatibility antigen HLA-C; major histocompatibility complex class I A; major histocompatibility HLA-Cw2.2 heavy chain; MGC184092; MGC7052; MHC 1; MHC Class 1; MHC class 1 antigen; MHC class I; MHC class I antigen heavy chain HLA-C; MHC class I antigen HLA-A heavy chain; MHC class I antigen HLA-B alpha chain; MHC class I antigen HLA-B heavy chain; MHC class I antigen SHCHA; MHC class I molecule; MHC class I-like alpha chain membrane-bound type; MHC HLA-A cell surface antigen; MHC HLA-A10-alpha-2 chain precursor; MHC HLA-A2.4a chain; MHC HLA-A24 cell surface glycoprotein; MHC HLA-ABC; MHC HLA-B cell surface glycoprotein; MHC HLA-B transmembrane glycoprotein; MHC HLA-B44; MHC HLA-B7 heavy chain precursor; MHC HLA-Bw46; MHC HLA-C-alpha-2 chain precursor; MHC I HLA; MHC1; similar to Homo sapiens MHC HLA-B39 mRNA with GenBank Accession Number L42024.1; subtype B*3508 differs at residue 156 (Leu->Arg) with subtype B*3501; unnamed protein product
基因别名: AS; B-4901; D6S204; HLA-A; HLA-B; HLA-C; HLA-JY3; HLAA; HLAB; HLAC; HLC-C; MHC; PSORS1
Entrez Gene ID: (Human) 3105, (Human) 3106, (Human) 3107